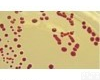
BJ-0011-1709 霉菌培养基（含<em>琼脂</em>和<em>氯霉素</em>）

Mag-Bind Forensic DNA Kit(200),M6225-02
CAS:584-08-7价格,碳酸钾价格,25g
CAS:370-81-0价格,双(环己酮)草酸二腙酯价格,25g
乙酸壬酯CAS:143-13-5,Nonylacetat,用于有机合成,
帕夏查耳酮,英文名称:Pashanone,规格:10mg
6-溴-2'-氯-3,3'-联吡啶价格,100mg
CAS:7752-82-1,2-氨基-5-溴嘧啶,英文名称:2-Amino-5-bromopyrimidine
CAS:254883-43-7价格,4-(2-氯-5甲基苯氧基)价格,250mg
CAS:80-59-1价格,顺芷酸;alfa-甲基巴豆酸价格,25g
CAS:29617-66-1,(S)-(-)-2-氯代丙酸,英文名称:(S)-(?)-2-Chloropropanoicacid
现GMS70014.5,体液谷氨酸酸转氨酶(GPT)活性光谱法定量检测试剂盒,20次
79069-14-0|N-Boc-L-缬氨醇,产品名称:N-Boc-L-缬氨醇 Cas No.:79069-14-0 含量:98%
CAS:4606-65-9,3-甲醇,英文名称:3-Piperidinemethanol
6960-42-5|7-Nitroindole,产品名称:7-Nitroindole Cas No.:6960-42-5 含量:98%
96T/48T,小鼠PEDF试剂盒说明书,色素上皮衍生因子Elisa试剂盒价格,小鼠PEDF试剂盒说明书,色素上皮衍生因子Elisa试剂盒价格
CAS:25873价格,2-溴苯乙酮价格,25g
CAS:1333-86-4,碳纳米管,纯度:1000%,规格:250g
CAS:114821-24-8,4-Cyano-2-iodopyridine,纯度:95%,规格:1g
CAS:120-29-6,α-托品醇,英文名称:Tropine
CAS:12036-22-5,氧化钨(IV),纯度:,规格:100g
AL5000DNAMarker?100,250,500,750,1000,2000,3000,5000bp,产地:,规格:250μl(50次)
199803-23-1|3-氯-2-[(4-甲基苯基)硫代]苯胺,产品名称:3-氯-2-[(4-甲基苯基)硫代]苯胺 Cas No.:199803-23-1 分子式:C13H12ClNS 分子量:249.76 含量:
CAS:635-65-4,胆红素/胆深红/胆红质/胆深素/Bilirubin(ex pig),BR,99%,1克,2~8℃,避光
C